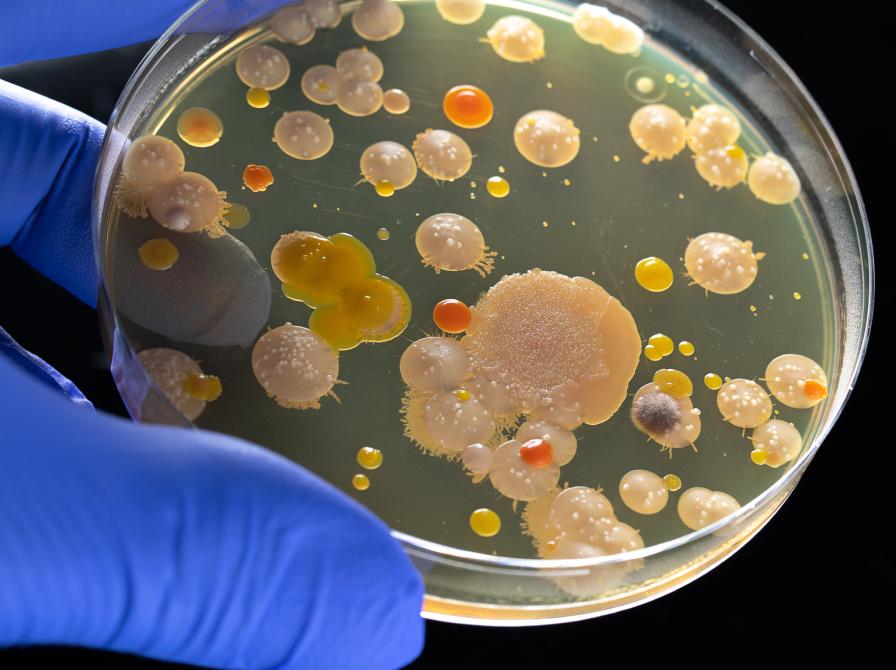
Petriskål med bakterier

Vil resistente bakterier slå os ihjel? ved Ditlev Brodersen og Hans Jørn Kolmos
Tags
Livestream- Date
- Udløbet
- Bibliotek
- Brønderslev Bibliotek
- I samarbejde med
- Borger9700
- Adresse
-
P. N. Jensens Plads 5
9700 Brønderslev
Danmark
I dette foredrag vil molekylærbiolog Ditlev E. Brodersen og læge og mikrobiolog Hans Jørn Kolmos fortælle om bakterier og antibiotika. De vil gøre dig klogere på, hvordan de små encellede organismer, bakterierne, ser ud indeni og udenpå, da det netop er bakteriernes opbygning og hvordan de adskiller sig fra menneskeceller, der er grunden til at antibiotika kan slå bakterierne ihjel uden at gøre større skade på os selv. Hør også om de forskellige typer af antibiotika og hvordan de dræber bakterier.
Det er gratis og deltage og kræver ingen tilmelding.
Der livestreames i bibliotekets Pejsestue - indgang via Mejerigade eller bibliotekets hovedindgang.